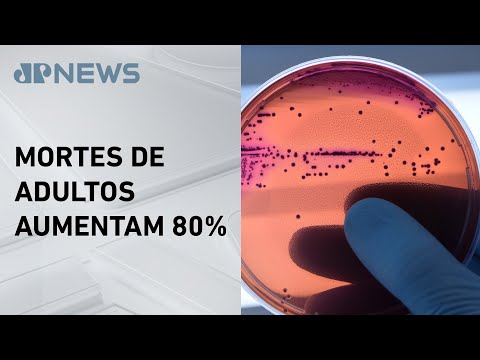

BUSCA AGROSOFT
Busca por data = "Dia: 19 - Mês: 09 - Ano: 2024" (mais recente para a mais antiga)1: CLIMATOLOGISTA ALERTA PARA ACELERAMENTO DOS EFEITOS DAS MUDANÇAS CLIMÁTICAS
 Publicado em 2024-09-19 18:45:03 por #TVCultura [397 hits]
Publicado em 2024-09-19 18:45:03 por #TVCultura [397 hits]
Dados de órgãos oficiais confirmam a aceleração dos efeitos das mudanças climáticas, que impressionam até os cientistas mais experientes, como o climatologista Carlos Nobre.
 Publicado em 2024-09-19 18:45:03 por #TVCultura [397 hits]
Publicado em 2024-09-19 18:45:03 por #TVCultura [397 hits]Dados de órgãos oficiais confirmam a aceleração dos efeitos das mudanças climáticas, que impressionam até os cientistas mais experientes, como o climatologista Carlos Nobre.
2: INFECÇÕES RESISTENTES A ANTIBIÓTICOS PODEM CAUSAR MAIS DE 39 MILHÕES DE MORTES
 Publicado em 2024-09-19 17:45:02 por #JovemPan [309 hits]
Publicado em 2024-09-19 17:45:02 por #JovemPan [309 hits]
Mais de 39 milhões de pessoas em todo o mundo podem morrer diretamente devido a infecções resistentes aos antibióticos nos próximos 25 anos.
Publicado em 2024-09-19 17:45:02 por #JovemPan [309 hits]
Publicado em 2024-09-19 17:45:02 por #JovemPan [309 hits]Mais de 39 milhões de pessoas em todo o mundo podem morrer diretamente devido a infecções resistentes aos antibióticos nos próximos 25 anos.
3: MEGATSUNAMI DE 200M BALANÇOU A TERRA E INTRIGOU A CIÊNCIA
 Publicado em 2024-09-19 16:45:05 por #OlharDigital [363 hits]
Publicado em 2024-09-19 16:45:05 por #OlharDigital [363 hits]
Quando cientistas perceberam que uma onda gigante atingiu a Groelândia no ano passado, deram início a uma série de investigações. Acompanhe!
 Publicado em 2024-09-19 16:45:05 por #OlharDigital [363 hits]
Publicado em 2024-09-19 16:45:05 por #OlharDigital [363 hits]Quando cientistas perceberam que uma onda gigante atingiu a Groelândia no ano passado, deram início a uma série de investigações. Acompanhe!
4: HÁ ALGO DE ESTRANHO NO SUBSOLO DE MARTE
 Publicado em 2024-09-19 15:45:04 por #OlharDigital [354 hits]
Publicado em 2024-09-19 15:45:04 por #OlharDigital [354 hits]
Existe algo estranho no subsolo de Marte e a ciência tem um plano para descobrir o que é. Confira na reportagem do Olhar Digital.
 Publicado em 2024-09-19 15:45:04 por #OlharDigital [354 hits]
Publicado em 2024-09-19 15:45:04 por #OlharDigital [354 hits]Existe algo estranho no subsolo de Marte e a ciência tem um plano para descobrir o que é. Confira na reportagem do Olhar Digital.
5: UBS, UPA E PRONTO-SOCORRO: SAIBA QUANDO PROCURAR CADA SERVIÇO
 Publicado em 2024-09-19 14:45:02 por #DrauzioVarella [418 hits]
Publicado em 2024-09-19 14:45:02 por #DrauzioVarella [418 hits]
Você está se sentindo mal e acha que é a hora de procurar um médico. E agora, qual serviço de saúde buscar primeiro? UBS, UPA ou pronto-socorro.
 Publicado em 2024-09-19 14:45:02 por #DrauzioVarella [418 hits]
Publicado em 2024-09-19 14:45:02 por #DrauzioVarella [418 hits]Você está se sentindo mal e acha que é a hora de procurar um médico. E agora, qual serviço de saúde buscar primeiro? UBS, UPA ou pronto-socorro.
6: ESCORE DE FEZES E O DESEMPENHO NO CONFINAMENTO
 Publicado em 2024-09-19 13:45:06 por #PecuáriadePrecisão [382 hits]
Publicado em 2024-09-19 13:45:06 por #PecuáriadePrecisão [382 hits]
Como o escore de fezes dos seus animais reflete a eficácia da dieta? Como essa análise pode orientar ajustes na alimentação para otimizar o desempenho dos animais no confinamento.
 Publicado em 2024-09-19 13:45:06 por #PecuáriadePrecisão [382 hits]
Publicado em 2024-09-19 13:45:06 por #PecuáriadePrecisão [382 hits]Como o escore de fezes dos seus animais reflete a eficácia da dieta? Como essa análise pode orientar ajustes na alimentação para otimizar o desempenho dos animais no confinamento.
7: SISTEMAS AGRÍCOLAS E DESAFIOS NA PRODUÇÃO DE BIOINSUMOS
 Publicado em 2024-09-19 12:45:04 por #CanaldoBoi [405 hits]
Publicado em 2024-09-19 12:45:04 por #CanaldoBoi [405 hits]
O Segundo Workshop sobre Microorganismos para uma Agricultura Sustentável abordou temas como sistemas agrícolas e desafios na produção de bioinsumos de base microbiana.
 Publicado em 2024-09-19 12:45:04 por #CanaldoBoi [405 hits]
Publicado em 2024-09-19 12:45:04 por #CanaldoBoi [405 hits]O Segundo Workshop sobre Microorganismos para uma Agricultura Sustentável abordou temas como sistemas agrícolas e desafios na produção de bioinsumos de base microbiana.
8: PESQUISA TRAZ NOVO MÉTODO DE ANÁLISE DO MILHO E DO SORGO
 Publicado em 2024-09-19 11:45:03 por #AgroMais [375 hits]
Publicado em 2024-09-19 11:45:03 por #AgroMais [375 hits]
Cientistas criaram uma maneira de avaliar a qualidade dos grãos sem destruir o material analisado. Dessa forma, o processo fica mais barato e a qualidade do alimento produzido no país aumenta.
 Publicado em 2024-09-19 11:45:03 por #AgroMais [375 hits]
Publicado em 2024-09-19 11:45:03 por #AgroMais [375 hits]Cientistas criaram uma maneira de avaliar a qualidade dos grãos sem destruir o material analisado. Dessa forma, o processo fica mais barato e a qualidade do alimento produzido no país aumenta.
9: FAZENDA TRÊS MENINAS: 1º LUGAR - PEQUENAS PROPRIEDADES - FAZENDA SUSTENTÁVEL
 Publicado em 2024-09-19 10:45:03 por #GloboRural [370 hits]
Publicado em 2024-09-19 10:45:03 por #GloboRural [370 hits]
A fazenda Três Meninas alcançou o primeiro lugar na categoria Pequenas Propriedades no 8º Prêmio Fazenda Sustentável do programa Globo Rural. Confira!
 Publicado em 2024-09-19 10:45:03 por #GloboRural [370 hits]
Publicado em 2024-09-19 10:45:03 por #GloboRural [370 hits]A fazenda Três Meninas alcançou o primeiro lugar na categoria Pequenas Propriedades no 8º Prêmio Fazenda Sustentável do programa Globo Rural. Confira!
10: ALOJAMENTO DOS PINTINHOS
 Publicado em 2024-09-19 09:45:05 por #Embrapa [3433 hits]
Publicado em 2024-09-19 09:45:05 por #Embrapa [3433 hits]
Este vídeo faz parte da Ater+ Digital Aves, sobre produção de frango de corte em pequena escala. Hoje vamos falar sobre Alojamento dos Pintinhos.
 Publicado em 2024-09-19 09:45:05 por #Embrapa [3433 hits]
Publicado em 2024-09-19 09:45:05 por #Embrapa [3433 hits]Este vídeo faz parte da Ater+ Digital Aves, sobre produção de frango de corte em pequena escala. Hoje vamos falar sobre Alojamento dos Pintinhos.
11: VAI FALTAR ÁGUA? SAIBA ONDE HÁ RISCO DE RESTRIÇÃO
 Publicado em 2024-09-19 08:45:04 por #JovemPan [370 hits]
Publicado em 2024-09-19 08:45:04 por #JovemPan [370 hits]
O debate sobre o uso da água tem ganhado força ao redor do mundo e elevado as tensões sobre o tema. No Brasil, o assunto ganhou destaque principalmente pelo tempo seco que atinge grande parte do país.
 Publicado em 2024-09-19 08:45:04 por #JovemPan [370 hits]
Publicado em 2024-09-19 08:45:04 por #JovemPan [370 hits]O debate sobre o uso da água tem ganhado força ao redor do mundo e elevado as tensões sobre o tema. No Brasil, o assunto ganhou destaque principalmente pelo tempo seco que atinge grande parte do país.
12: O VERDADEIRO QUARTO DE MILHA: O SEGREDO POR TRÁS DOS CAMPEÕES DE CORRIDA
 Publicado em 2024-09-19 07:45:02 por #RichardRasmussen [424 hits]
Publicado em 2024-09-19 07:45:02 por #RichardRasmussen [424 hits]
Olá, eu sou Richard Rasmussen e hoje vamos conhecer o universo dos cavalos Quarto de Milha, uma das raças mais rápidas e impressionantes do mundo.
 Publicado em 2024-09-19 07:45:02 por #RichardRasmussen [424 hits]
Publicado em 2024-09-19 07:45:02 por #RichardRasmussen [424 hits]Olá, eu sou Richard Rasmussen e hoje vamos conhecer o universo dos cavalos Quarto de Milha, uma das raças mais rápidas e impressionantes do mundo.
13: CARNE DE FRANGO ALCANÇA MAIOR PREÇO MÉDIO EM DOIS ANOS
 Publicado em 2024-09-19 06:45:10 por #Record [367 hits]
Publicado em 2024-09-19 06:45:10 por #Record [367 hits]
Valor superou US$ 2 mil por tonelada e foi o maior pago desde agosto de 2022. Confira na reportagem o Record News Rural.
 Publicado em 2024-09-19 06:45:10 por #Record [367 hits]
Publicado em 2024-09-19 06:45:10 por #Record [367 hits]Valor superou US$ 2 mil por tonelada e foi o maior pago desde agosto de 2022. Confira na reportagem o Record News Rural.
14: PRODUÇÃO DE GRÃOS CAI 10% POR CONTA DO CLIMA SEVERO
 Publicado em 2024-09-19 05:45:07 por #JovemPan [345 hits]
Publicado em 2024-09-19 05:45:07 por #JovemPan [345 hits]
As queimadas e as secas prolongadas estão destruindo plantações por todo o Brasil, afetando a produção agrícola e causando aumento nos preços dos grãos e da carne.
 Publicado em 2024-09-19 05:45:07 por #JovemPan [345 hits]
Publicado em 2024-09-19 05:45:07 por #JovemPan [345 hits]As queimadas e as secas prolongadas estão destruindo plantações por todo o Brasil, afetando a produção agrícola e causando aumento nos preços dos grãos e da carne.
15: LIXO RECICLÁVEL GERA DESCONTO NA CONTA DE LUZ
 Publicado em 2024-09-19 04:45:05 por #CNN [443 hits]
Publicado em 2024-09-19 04:45:05 por #CNN [443 hits]
Para estimular A separação e coleta de lixo um programa que existe em pelo menos 13 estados brasileiros oferece descontos, como na conta de luz, para quem levar o lixo reciclável até um eco ponto.
 Publicado em 2024-09-19 04:45:05 por #CNN [443 hits]
Publicado em 2024-09-19 04:45:05 por #CNN [443 hits]Para estimular A separação e coleta de lixo um programa que existe em pelo menos 13 estados brasileiros oferece descontos, como na conta de luz, para quem levar o lixo reciclável até um eco ponto.